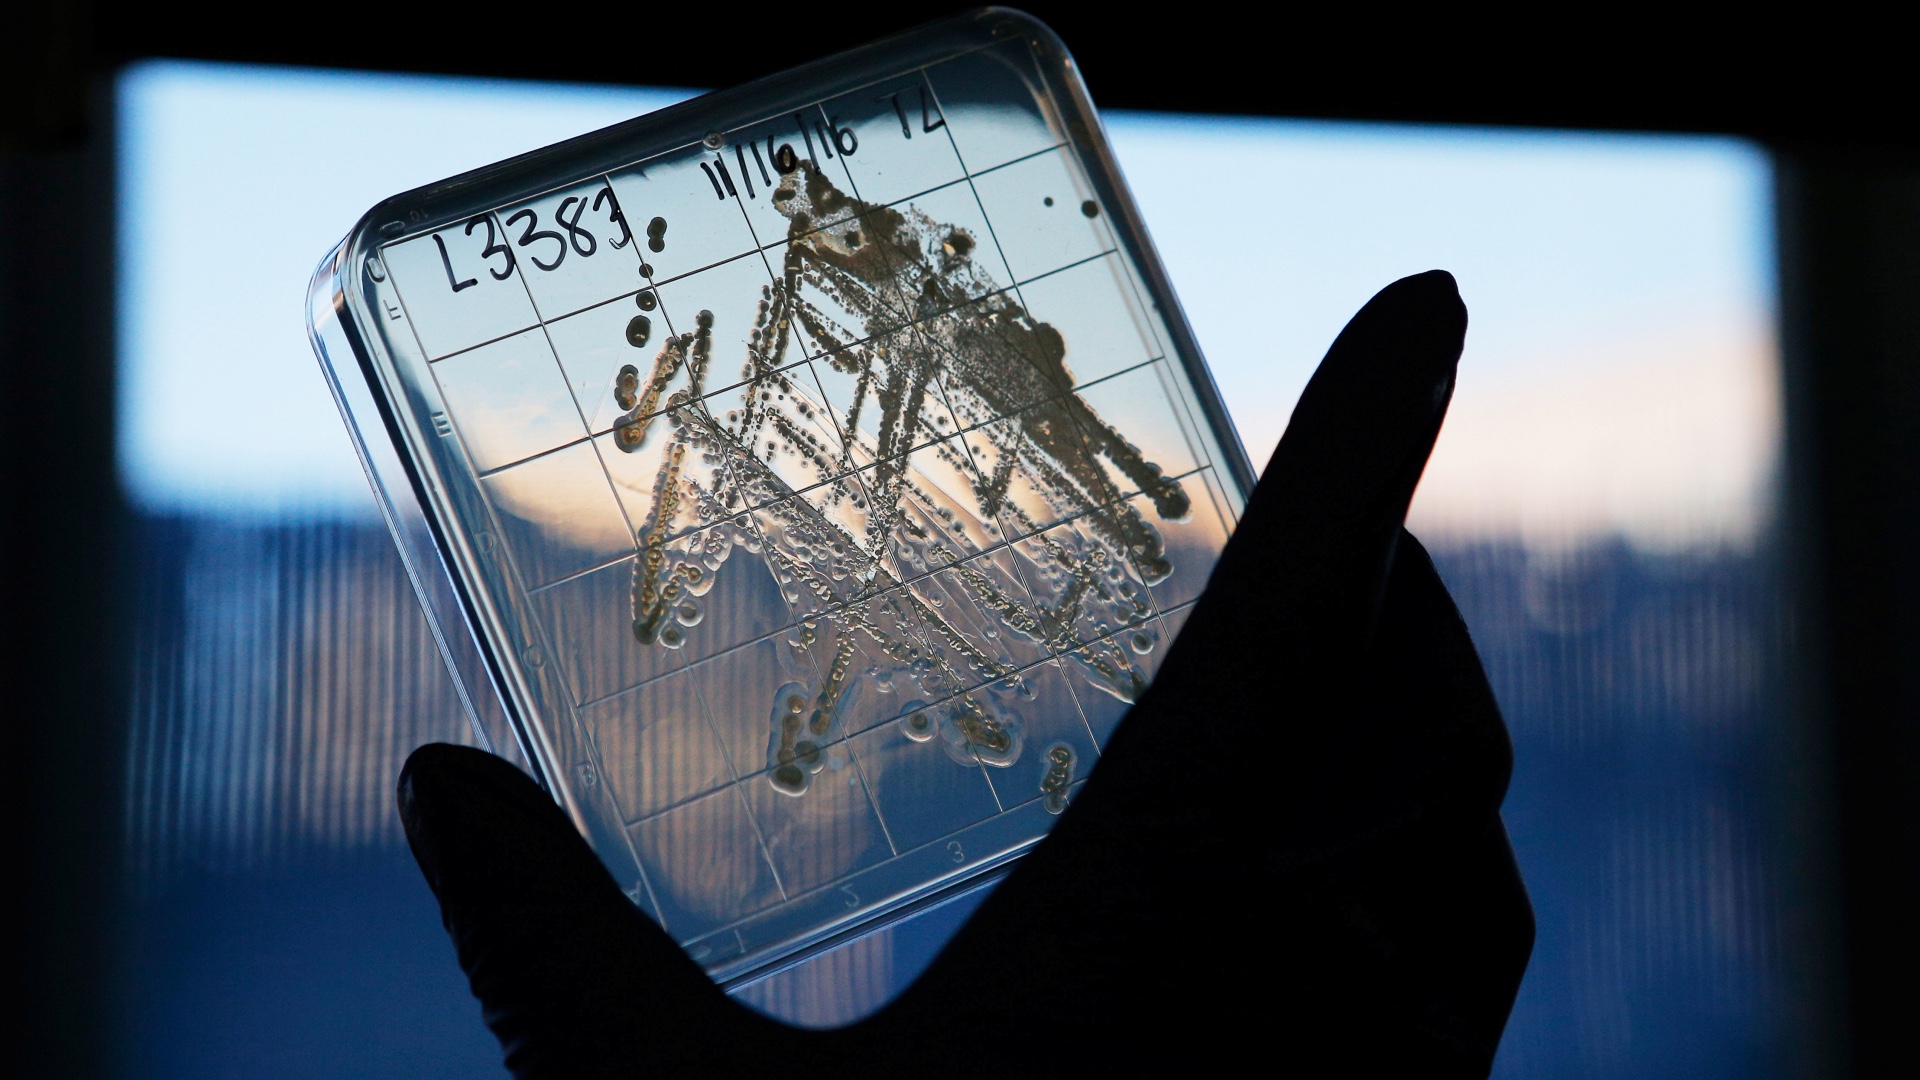
Doctor''s note - antibiotics

Doctor’s Note: How COVID-19 is increasing antibiotic resistance
Why has the WHO said a ‘worrying number’ of bacterial infections are becoming resistant to medicines?
Doctors and scientists have long spoken about the world sleepwalking towards an “antimicrobial apocalypse” – where antibiotics used to treat some of our most common and serious infections are rendered useless as bacteria grow resistant to them. These experts have said urgent action is needed if we want to continue to be able to treat bacterial infections effectively in the future.
Antibiotics are one of our most useful medications. There are many different types and they work in a variety of ways, but essentially they all have the same goal: to stop bacteria that cause infections from multiplying and spreading. They are used to treat simple chest and throat infections but also in hospitals to treat more serious infections such as meningitis and sepsis.
Without antibiotics, infections can run rife inside the human body causing widespread damage and even death. Without them, the infections we normally treat quite effectively will begin to increase and we will be left with no medicine with which to fight them.
Antimicrobial resistance
In recent months, the coronavirus pandemic is thought to have accelerated the threat of global antimicrobial resistance as many patients admitted to hospital with COVID-19 receive antibiotics to keep secondary bacterial infections, such as bacterial pneumonia, in check.
WHO Director-General Tedros Adhanom Ghebreyesus said in March that a “worrying number” of bacterial infections were becoming increasingly resistant to the antibiotics normally used to treat them.
Senior scientific adviser to the US Centers for Disease Control and Prevention (CDC), Dawn Sievert has also said, “Since the emergence of COVID-19, collected data have shown an increase in antibiotic use, even though most of the initial illnesses being treated have been from COVID-19 viral infection.”
It is not only those who are admitted to hospital who are receiving antibiotics; people with mild to moderate COVID-19 symptoms such as cough and fever are also being given prophylactic antibiotics in case they develop bacterial infections. This is not useful, as COVID-19 is a viral infection and antibiotics are ineffective against viruses. But some doctors who may be concerned about a risk of a secondary bacterial infection are prescribing them.
Infections are caused by many different types of bugs: bacteria, viruses, parasites and fungi, to name a few. But antibiotics do not work on viruses, parasites or fungi as they have a different cell makeup and way of dividing.
The common cold, most sore throats and sore ears are caused by viral infections. More serious viral infections such as HIV and viral hepatitis may be treated with specific anti-viral drugs, but not antibiotics. Infections such as malaria are caused by a parasite and need to be treated with special drugs that are not antibiotics. And common fungal infections including thrush are usually treated with antifungals.
How do bacteria become resistant to antibiotics?
Antibiotics are only effective in treating bacterial infections.
There are several different groups of antibiotics that target different groups of bacteria. A clinician should only prescribe antibiotics for a patient when a bacterial infection is suspected and when it is likely that antibiotics are the most effective way to treat the infection.
Antibiotics work in a variety of ways to either kill bacteria or stop them from multiplying.
Bacteria can multiply at such a rate that they can double their numbers every 20 minutes in ideal conditions. This is how infections take hold and spread. This rapid rate of multiplication leads to large numbers of random mutations taking place within the bacterial population. Most mutations are harmful to the bacteria and do not benefit it in any way.
However, as more and more people use antibiotics to treat infections, a mutation will randomly take place every now and again that is advantageous to the bacteria and makes it resistant to the effect of the antibiotic.
This means those bacteria without the mutation are susceptible to the medicine and are killed, but those with the new mutation can continue to reproduce and create a whole new colony of bacteria that are now resistant to that antibiotic.
The more antibiotics we use, the more we push bacteria in the direction of new mutations – and increase resistance. If we were to use fewer antibiotics, these mutations would likely happen less frequently and would not be so advantageous to the bacteria.
How might the pandemic cause an increase in antimicrobial resistance?
Although COVID-19 is caused by a virus, patients with severe symptoms can develop complications as their lungs weaken and fluid starts to build. This fluid attracts bacteria and they can cause pneumonia.
Patients are given antibiotics either before this happens to prevent pneumonia or to treat the infection once it has set in. But studies have shown that antibiotics have also been used to treat mild symptoms, when there was a low risk of developing pneumonia. This number was particularly high for those patients being treated in Wuhan, China.
Scientists have also warned that clinicians face a level of uncertainty when patients present with COVID-19 symptoms including a fever and cough that means some clinicians will use their “standard reflex” and prescribe antibiotics in the first instance.
This, combined with the lack of an effective treatment for the coronavirus and high mortality rate, means there has been an increase in antibiotic prescribing.
Another risk of antibiotic misuse comes from premature misinformation about therapies for COVID-19.
Some media reports and political leaders talked extensively about the possible use of the antibiotic azithromycin in combination with the drug hydroxychloroquine, despite the lack of clinical evidence for their effectiveness.
While antibiotics may play a role in the treatment of those who have severe symptoms of COVID-19 and require hospitalisation, scientists warn that there will be a time after the COVID-19 outbreak where we will go back to fighting infections we have always been battling against and antibiotics will have a crucial role in this.
We must not lose sight of long-term problems that may be exacerbated by this global pandemic. Worldwide antibiotic resistance may well be one of those problems.
